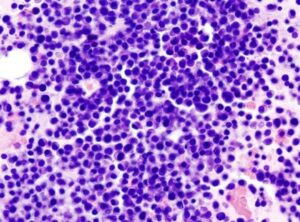

JUAN RIERA ROCA
El grupo municipal del PP en el Ayuntamiento de Palma, a través de la regidora Lydia Pérez, ha denunciado que “ninguno de los nuevos autobuses de la EMT en circulación comprados por el gobierno del alcalde Hila dispone de cinturón de seguridad para personas con movilidad reducida en silla de ruedas y para los cochecitos de bebé, un elemento de seguridad que sí tienen las unidades más antiguas”.
Por esa razón, el PP preguntará al equipo de gobierno de izquierdas las razones por las cuales ninguno de los nuevos buses que actualmente están en circulación, que han supuesto un desembolso de 32,5 millones de euros públicos, disponen de cinturón de seguridad e instarán al equipo de gobierno a dotar a las nuevas unidades de este elemento de seguridad.
Con esta propuesta, la formación se hace eco de las quejas elevadas por usuarios de la EMT con movilidad reducida y que se recogen hoy en un vídeo que el PP de Palma ha divulgado a través de sus cuentas en las redes sociales.
La formación también acusa al alcalde Hila de haberse “desentendido” de las cuestiones relacionadas con “la seguridad tanto para los pasajeros como para los conductores”, como lo constata el hecho que una remesa de las unidades adquiridas “no incorporaban la correspondiente mampara protectora para el conductor y ahora se están instalando, lo que supone un coste adicional a lo ya abonado y reafirma la pésima gestión del PSOE al frente de la EMT”.
Lydia Pérez ha alertado que “la Dirección de la EMT está siendo continuamente cuestionada” desde la revolución de diciembre, que implicó la eliminación de bastantes líneas y paradas, entre otras medidas, lo que ha generado “un ambiente de crispación entre trabajadores y usuarios” que ha sido determinante en la convocatoria de paros y de una huelga de trabajadores que está a punto de empezar.
“La EMT vive una situación límite mientras el alcalde Hila y el presidente de la empresa, el socialista Francesc Dalmau han estado de vacaciones sin sentarse a hablar con los trabajadores, ni tomar decisiones para mejorar el servicio. No son conscientes de que mucha gente se ha quedado sin línea y sin bus cerca de su casa o trabajo”, ha apuntado Lydia Pérez.